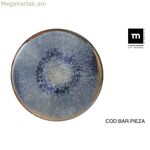

Երաշխիքներ և իսկություն։ Bbay-ի կատալոգում ներկայացված ամբողջ արտադրանքը 100% օրիգինալ է։ Ապրանքատեսականին ներմուծվում է Եվրոպայից, ապահովելով որակի եվրոպական ստանդարտներ և օրինական շրջանառություն: Ապրանքների վրա տարածվում է եվրոպական երաշխիք:
- Արտադրող: La Mediterránea
- Артикул: 4899888788560
- Առկա է: 0
- Միավոր: Միավոր
- Քաշը: 6.52
17647Դրամ
Ապրանքի նկարագրությունը բացակայում է